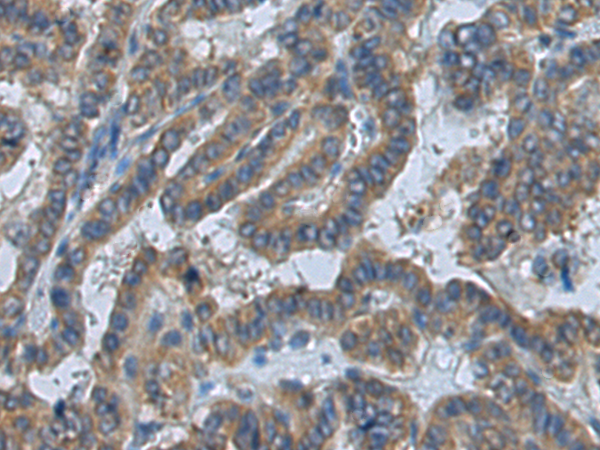

中文名稱(chēng): 兔抗ATP6V1D多克隆抗體
|
Background: |
This gene encodes a component of vacuolar ATPase (V-ATPase), a multisubunit enzyme that mediates acidification of eukaryotic intracellular organelles. V-ATPase dependent organelle acidification is necessary for such intracellular processes as protein sorting, zymogen activation, receptor-mediated endocytosis, and synaptic vesicle proton gradient generation. V-ATPase is composed of a cytosolic V1 domain and a transmembrane V0 domain. The V1 domain consists of three A and three B subunits, two G subunits plus the C, D, E, F, and H subunits. The V1 domain contains the ATP catalytic site. The V0 domain consists of five different subunits: a, c, c', c", and d. Additional isoforms of many of the V1 and V0 subunit proteins are encoded by multiple genes or alternatively spliced transcript variants. This gene encodes the V1 domain D subunit protein. |
|
Applications: |
ELISA, WB, IHC |
|
Name of antibody: |
ATP6V1D |
|
Immunogen: |
Fusion protein of human ATP6V1D |
|
Full name: |
ATPase H+ transporting V1 subunit D |
|
Synonyms: |
VATD; VMA8; ATP6M |
|
SwissProt: |
Q9Y5K8 |
|
ELISA Recommended dilution: |
5000-10000 |
|
IHC positive control: |
Human thyroid cancer and Human colorectal cancer |
|
IHC Recommend dilution: |
100-300 |
|
WB Predicted band size: |
28 kDa |
|
WB Positive control: |
Human fetal brain tissue lysate |
|
WB Recommended dilution: |
500-2000 |

購(gòu)物車(chē)
幫助
021-54845833/15800441009
